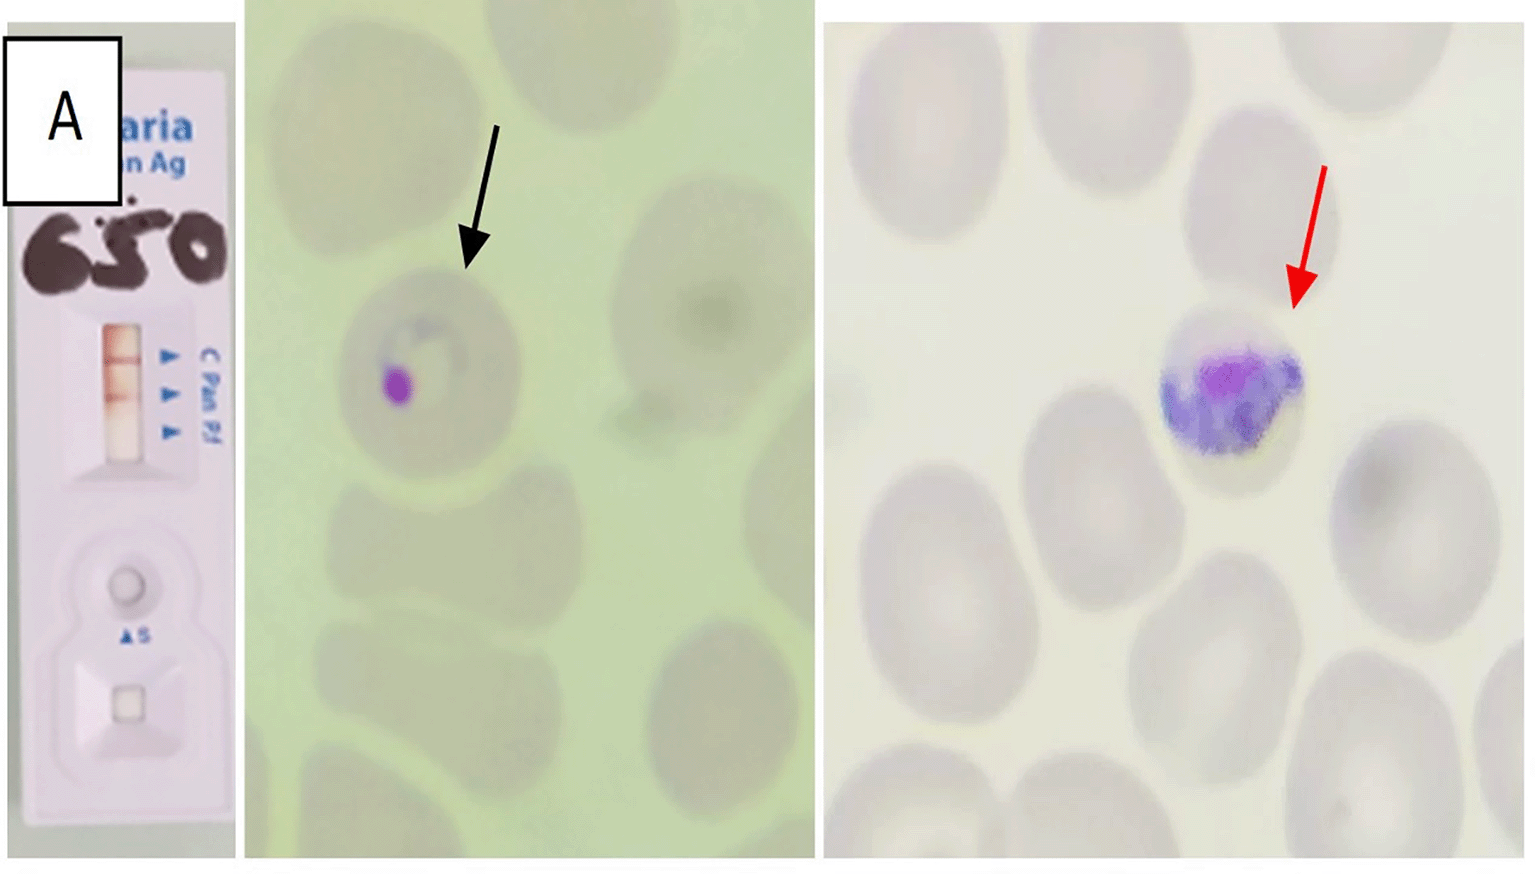
2953d5ab-6f69-4702-b432-666239f77e0a_figure1.gif
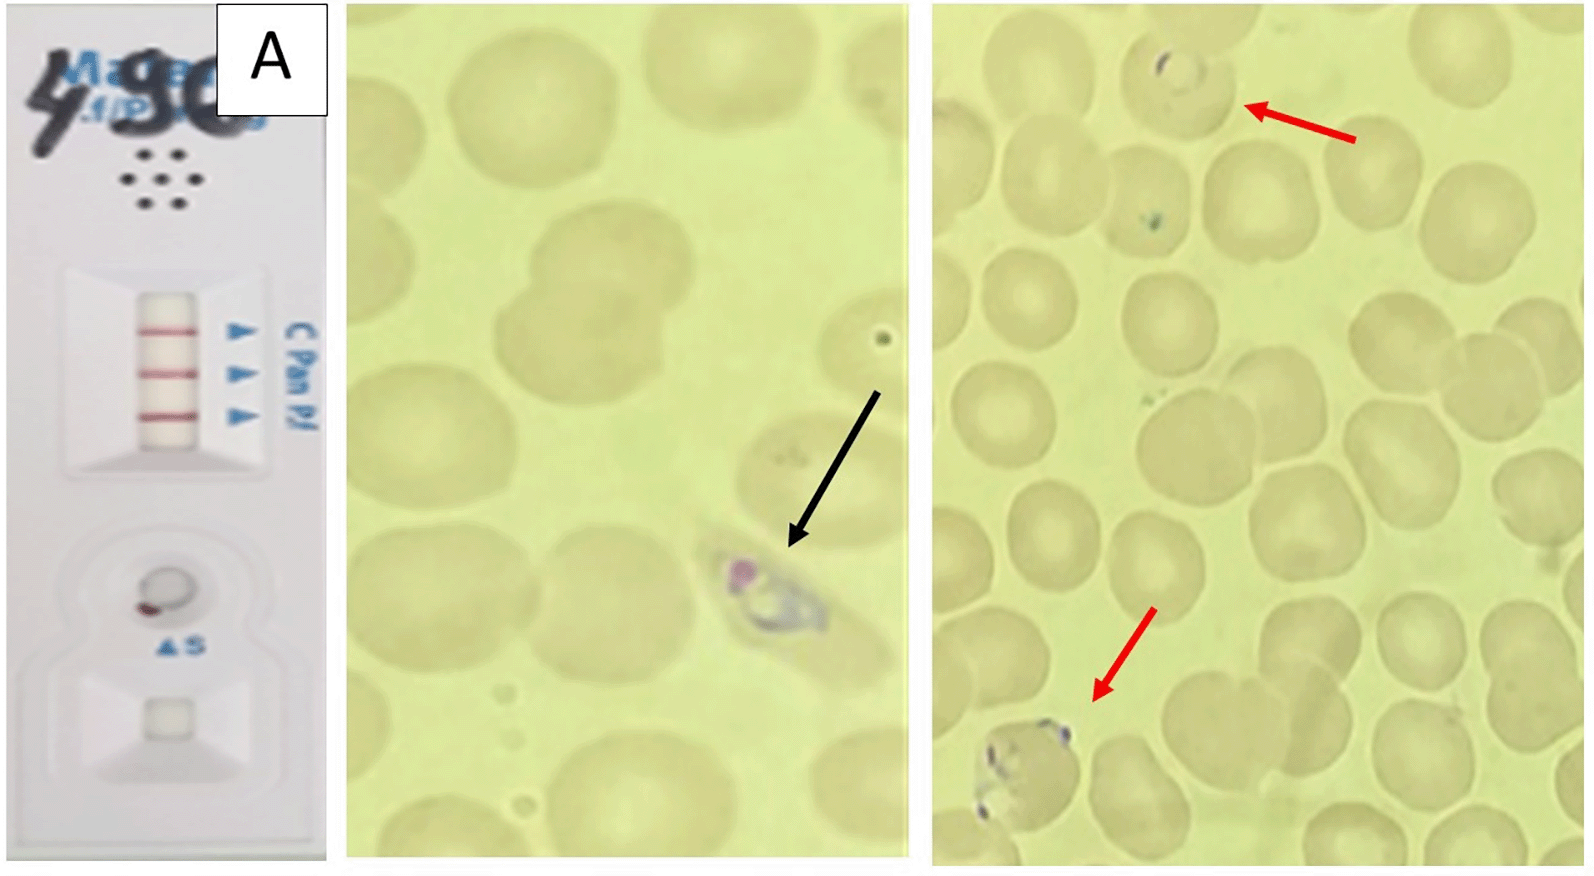
2953d5ab-6f69-4702-b432-666239f77e0a_figure3.gif

Keywords
Malaria, mixed infection, Plasmodium, military
This article is included in the Emerging Diseases and Outbreaks gateway.
Malaria is a life-threatening vector-borne disease caused by five species of the genus Plasmodium (P.) It can present as mixed infections that remain underreported and pose diagnostic, therapeutic and prognostic challenges.
The objective of the present study was to describe the epidemiological, clinical, and biological features of four cases of mixed Plasmodium infection.
This retrospective descriptive study included cases of mixed Plasmodium infections diagnosed at the Parasitology Laboratory of the Military Hospital of Tunis between 2022 and 2025. Diagnosis was established using May–Grünwald–Giemsa–stained thin blood smears, Giemsa–stained thick smears, and rapid diagnostic tests. Plasmodium species were identified according to standard microscopic morphological criteria.
We report four cases of mixed Plasmodium infection diagnosed in military personnel returning from deployment in Central Africa. The patients were aged 31–52 years (mean age 38.8 years) with sex ratio 3. They presented within 10–30 days post-return with fever (38–42 °C) associated with headache, myalgia, abdominal pain, and/or vomiting. All had adhered to malaria chemoprophylaxis, and three reported no prior malaria episodes, while one patient had a history of six previous attacks. Rapid diagnostic tests were positive for pan-Plasmodium pLDH in all cases; two patients were also positive for HRP2. Peripheral blood smears confirmed mixed infections. Parasitemia was generally low (<1% in three cases, 1% in one case). Treatment consisted of artemether–lumefantrine (Coartem®) for all patients, combined with primaquine for those with P. ovale infection. Clinical evolution was favorable in all cases, and follow-up blood smears on days 3, 7, and 28 confirmed parasitological clearance, with only rare degenerated trophozoites observed in one patient on day 3.
Mixed Plasmodium infections can influence disease severity, treatment outcomes, and drug resistance. Accurate diagnosis and radical therapy are keys to preventing relapses.
Malaria, mixed infection, Plasmodium, military
Malaria is a life-threatening vector-borne disease caused by five species of the genus Plasmodium (P.). The most common species involved in human malaria are Plasmodium falciparum, Plasmodium vivax, Plasmodium malariae, Plasmodium ovale, and Plasmodium knowlesi. The infection involves usually a single species. Mixed Plasmodium infection (MPI) refers to the simultaneous infection with more than one species of the malaria-causing parasite Plasmodium.1
MPI are undereported in the literature but relatively common, especially in regions where multiple Plasmodium species coexist.1,2 In some African and Asian regions, mixed infections are found in up to 4% of malaria-positive cases. Although, this number may be underestimated due to diagnostic challenges because traditional microscopy may miss one of the infecting species, especially when there is a dominance of one species in the blood.1,3
MPI can be associated with severe malaria.4 Notably, severe complications in mixed infections may involve severe anemia, pulmonary failure, and renal impairment. Furthermore, patients with mixed infections may experience a higher likelihood of multiple organ failure compared to those with single-species infections.5
After treatment, patients with MPI have a higher risk of malaria recurrence, especially within the first month following therapy, as compared to those with single-species infections.6 The choice of antimalarial treatment is critical, to ensure clearance of all Plasmodium species and prevent relapses.5,6
Given the diagnostic, therapeutic, and prognostic difficulties, we report in this study the epidemiological, clinical, and biological characteristics of four cases of MPI diagnosed in military personnel returning from deployment and treated at the Military Hospital in Tunis.
This retrospective descriptive study included cases of mixed Plasmodium infections diagnosed at the Parasitology Laboratory of the Military Hospital of Tunis between 2022 and 2025. Diagnosis was established using May–Grünwald–Giemsa–stained thin blood smears, Giemsa–stained thick smears, and rapid diagnostic tests. Plasmodium species were identified according to standard microscopic morphological criteria.
Over a four-year period (2022-2025), we identified four cases of MPI among a total of 175 cases of imported malaria in Tunisian military personnel returning from missions in endemic areas. This represents a prevalence of 2.2%. All four cases had stayed in Central Africa and were recorded in 2024 (n = 3) and 2025 (n = 1).
The patients were aged 31–52 years (mean age 38.8 years) with sex ratio 3. They presented within 10–30 days post-return with fever (38–42°C) associated with headache, myalgia, abdominal pain, and/or vomiting. All had adhered to malaria chemoprophylaxis, and three reported no prior malaria episodes, while one patient had a history of six previous attacks (patient 3).
Rapid diagnostic tests (RDT) were positive for pan- Plasmodium pLDH (PAN) in all cases; two patients were also positive for HRP2 (specific for P. falciparum). Peripheral blood smears confirmed mixed infections: P. falciparum and P. malariae in one patient, P. ovale and P. malariae in one patient, and P. falciparum and P. ovale in two patients. Parasitemia was generally low (<1% in three cases, 1% in one case).
Treatment consisted of artemether–lumefantrine (Coartem® 20 mg/120 mg) for all patients, administered at a dosage of 4 tablets at H0, H8, H24, H36, H48, and H60. It was combined with primaquine in three patients (those with P. ovale infection), at a dosage of 30 mg/day for 15 days. All patients adhered fully to the prescribed treatment, and no adverse or unanticipated events were observed during therapy.
Clinical evolution was favorable in all cases, and follow-up blood smears on days 3, 7, and 28 confirmed parasitological clearance, with only rare degenerated trophozoites observed in one patient on day 3.
Tables 1 and 2 summarized the main epidemiological, clinical, and biological features of the four patients. Figures 1, 2, 3, and 4 correspond to the parasitological diagnostic results of patients 1 to 4, respectively, including rapid diagnostic tests and blood smears.

This study provides a detailed description of four MPI in military personnel returning from Central Africa, with thorough documentation of clinical features, diagnostic tests, and follow-up parasitological clearance, which represents strength. Limitations include the small sample size, retrospective design, lack of molecular confirmation, and the exclusive focus on military personnel. Despite these constraints, the cases highlight that mixed infections can occur even under chemoprophylaxis, may present with low parasitemia, and require careful species identification.
MPI are underreported, but they are more common than previously thought, especially in regions where multiple species coexist. These infections may go undetected due to the dominance of one species or low parasitemia.
Studies in African and Asian endemic areas report prevalence rates ranging from 2% to 30%, depending on local transmission intensity and the sensitivity of diagnostic tools.7–9 The prevalence of MPI in our study was 2.2%. It reports four cases: one involving P. falciparum and P. malariae, one involving P. ovale and P. malariae, and two involving P. falciparum and P. ovale.
In Tunisia, MPI remain poorly documented. Bouratbine A. et al. reported five cases of MPI among 240 Plasmodium infections (1980-1995), including P. falciparum–P. ovale (2 cases), P. falciparum–P. malariae (2 cases), and P. falciparum–P. vivax (1 case).10 Belhadj et al. found six cases of MPI among 291 Plasmodium infections (1991-2006), with a similar distribution: P. falciparum–P. ovale (4 cases), P. falciparum–P. malariae (1 case), and P. falciparum–P. vivax (1 case).11 More recently, Siala et al. reported two cases of PMI: P. falciparum–P. ovale and P. falciparum–P. malariae.12
MPI can result from several factors. Multiple Anopheles species may transmit different Plasmodium species simultaneously in a single inoculation, or a single Plasmodium species may be introduced through successive bites by infected mosquitoes. P. vivax and P. ovale can persist as liver hypnozoites, causing relapses, while P. falciparum may recrudesce due to drug-resistant forms. Incomplete treatment of a prior infection can also lead to persistent or mixed parasitemia. These mechanisms highlight the complexity of diagnosing and managing mixed malaria infections in endemic areas.4–8
Accurate identification of mixed infections is crucial for appropriate management. Peripheral blood smear microscopy remains the gold standard for species identification and quantification, allowing detection of multiple species. However, it may fail to detect low-density parasitemia or minor species. Rapid diagnostic tests (RDTs) are valuable for rapid screening, detecting pan-Plasmodium antigens and species-specific markers, but they have known limitations, as some minor infections may yield false-negative results.13,14 Molecular techniques, such as PCR especially multiplex, nested approaches or real-time PCR, offer superior sensitivity and specificity, capable of identifying submicroscopic infections and clarifying complex species combinations.1,2,15,16 Metagenomic next-generation sequencing (mNGS) is a powerful tool for detecting mixed infections, useful in atypical or severe cases where routine tests fail, but its cost and complexity limit malaria use in endemic regions.17 Incorporating multiple diagnostic approaches can improve detection and guide targeted therapy.
Treatment of mixed infections should aim to eliminate all infecting species and prevent relapses. In our cases, artemether–lumefantrine was used for all patients, complemented by primaquine for P. ovale infections to target dormant liver stages. This combined approach resulted in rapid clinical recovery and confirmed parasitological clearance by day 28.
Appropriate management of mixed Plasmodium infection requires selecting antimalarial regimens effective against all infecting species. Artemisinin-based combination therapies (ACT) are effective against P. falciparum and non- falciparum species. Additional drugs such as primaquine are needed to eliminate hepatic stages of P. vivax and P. ovale.18 Treatment should be based on an ACT with the addition of primaquine when indicated and once G6PD deficiency has been excluded for radical cure in cases involving P. vivax or P. ovale.
Early intervention and adherence to recommended treatment protocols are critical, as untreated or inadequately treated mixed infections may contribute to severe disease manifestations, prolonged illness, and potential development of antimalarial resistance.18,19 Our findings reinforce the need for clinicians to consider species-specific therapies in co-endemic settings.
Preventive strategies remain essential to reduce the incidence and impact of malaria, particularly for travelers and military personnel deployed in endemic areas. Effective measures include adherence to chemoprophylaxis, use of insecticide-treated bed nets, application of topical repellents, and prompt medical evaluation at the onset of fever or other malaria symptoms. Education and awareness of the risk of these infections are also vital.20 Strengthening preventive programs and surveillance can help mitigate the burden of imported and co-endemic malaria cases.
Mixed Plasmodium infections, frequently underdiagnosed, pose diagnostic, therapeutic, and prognostic challenges, particularly in travelers and military personnel returning from endemic areas. Our case series highlights the importance of combining microscopy, rapid diagnostic tests, and, when available, molecular methods to ensure accurate species identification. Timely administration of appropriate ACT complemented by primaquine for relapsing species, resulted in full recovery and parasitological clearance in all cases. Optimizing diagnostic approaches, adherence to treatment guidelines, and reinforcing preventive measures remain essential to reduce the burden and complications of mixed malaria infections.
Written informed consent for the publication of clinical details was obtained from all patients.
All data underlying the results are included within the article, and the CARE Checklist is openly available in public repositories (Mtibaa L. CARE checklist – Mixed Plasmodium infection [Data set]. Zenodo; 2025. DOI: https://doi.org/10.5281/zenodo.17650886 under a CC0 1.0 license.)
| Views | Downloads | |
|---|---|---|
| F1000Research | - | - |
|
PubMed Central
Data from PMC are received and updated monthly.
|
- | - |
Is the background of the cases’ history and progression described in sufficient detail?
Yes
Are enough details provided of any physical examination and diagnostic tests, treatment given and outcomes?
Partly
Is sufficient discussion included of the importance of the findings and their relevance to future understanding of disease processes, diagnosis or treatment?
Partly
Is the conclusion balanced and justified on the basis of the findings?
Partly
Competing Interests: No competing interests were disclosed.
Reviewer Expertise: Vector-borne diseases specialised in Malaria
Alongside their report, reviewers assign a status to the article:
| Invited Reviewers | |
|---|---|
| 1 | |
|
Version 1 10 Dec 25 |
read |
Provide sufficient details of any financial or non-financial competing interests to enable users to assess whether your comments might lead a reasonable person to question your impartiality. Consider the following examples, but note that this is not an exhaustive list:
Sign up for content alerts and receive a weekly or monthly email with all newly published articles
Already registered? Sign in
The email address should be the one you originally registered with F1000.
You registered with F1000 via Google, so we cannot reset your password.
To sign in, please click here.
If you still need help with your Google account password, please click here.
You registered with F1000 via Facebook, so we cannot reset your password.
To sign in, please click here.
If you still need help with your Facebook account password, please click here.
If your email address is registered with us, we will email you instructions to reset your password.
If you think you should have received this email but it has not arrived, please check your spam filters and/or contact for further assistance.
Comments on this article Comments (0)